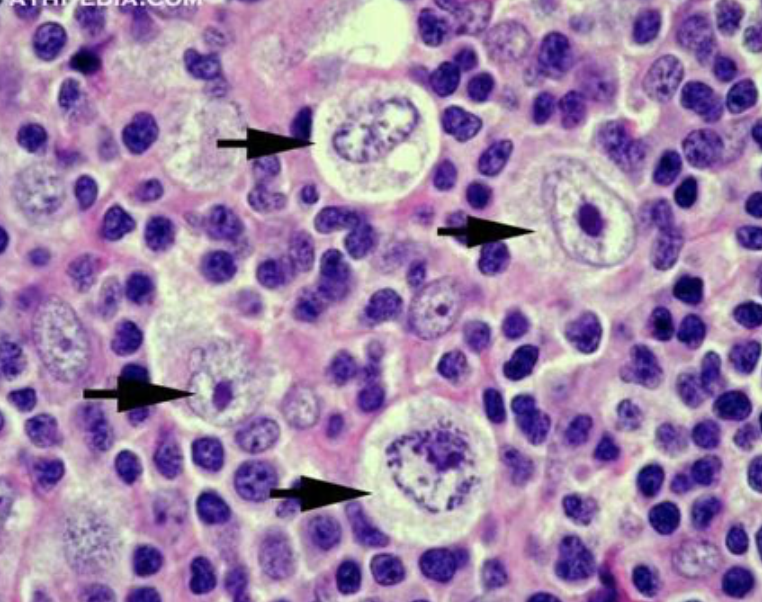

What is the difference between Hodgekin’s and Non-Hodgkin’s lymphomas?
The presence of Reed-Sternberg cell if present:
- Hodgekin’s lymphoma
- also possible: presence of Hodgekin-cells
What is a Reed-Sternberg cell?
The defining type of cells for Hodgekin’s lymphoma
- giant, irregular cells
- binucleated
- normally derived from B-lymphocytes
- look like owel eyes
- (often surrounded by no-maglignant inflammatory cells), T and eosinophils

What are characteristics of Hodgekin’s lymphomas?
- usually derive from B-cells
- spread in continous manner
- to nearby lymph nodes
- rarely to extranodal sites
What is the normal time in which Hodgekin’s lymphomas arise?
Bimodal distribution
- young adults around 20
- old üeople >60

What are the main subgroups of Hodgekin’s lymphoma?
- Classical
- Reed-Sternberg don’t express normal B-cell markers (CD20+45 but do express CD15)
- With 4 subtypes
- Reed-Sternberg don’t express normal B-cell markers (CD20+45 but do express CD15)
- Non-Classical
- Reed-Sternberg cells express CD20+45 but not 15+30
How many sub-types of Hodgekin’s lymphomas are there?
7 subtypes
- B-cell
- Follicular
- Burkit
- Tranlocation 8-14
- EBV associated
- Extranodal involvement
- Mantle Cell
- Lymphoplasmacytic Lymphoma
- Adult T-cell lymphoma (leukemia)
- Mycosis Fungoides
What are B-symptoms?
What do they indicate?
Weith loss
Night Sweat and
Fever
–> common in leukemias and lymphomas
What are the characteristics of non-Hodgekin’s lymphomas?
Normally spread non-continously
- involvement of extranodal sites
- GI
- Skin
- Brain
- usually no reed-sternberg cells
What is a Hodgekin cell?
What is it characteristic of?
It is a large, mononuclear lymphocyte
What are presenting symptoms of a patient with Hodgekin lymphoma?
Normally present with
- cervical persistant lymphadenopathy
- B-symptoms (30%)
- generalised pruritus
- and alcohol-induced pain at involved sites
What are the presenting symptoms of a patient with non-Hodgekin lymphoma?
Very different presentation (involves over 30 conditions)
- Agressive Lymphomas
- B-symptoms, malaise, SOB, cough, abdominal discomfort, anaemia, fatigue, change in mental status
- P. with low-grade often are asymptomatic
What are possible presenting signs in patient with non-hodgekin lymphomas?
- Signs may include lymphadenopathy,
- pallor (anaemia),
- purpura (thrombocytopenia),
- jaundice (liver failure),
- hepatomegaly,
- splenomegaly,
- skin nodules
- abnormal neurological examination.
What are possible signs of Hodgekin-lymphomas?
Palpation of all lymph nodes (cervical, inguinal, supraclavicular, axillary)
Hepato+splenomegaly
What is the aetiology of Hodgekin’s lymphomas?
- unclear, multifactoral
- infective (e.g. EBV)
- genetic-predisposition
What are risk factors for developing Hodgekin’s lymphomas?
- history of Epstein-Barr virus (EBV) infection
- family history of Hodgkin’s lymphoma
- young adults from higher socio-economic class
- HLA types
What is the aetiology of non-Hodgekin lymphomas?
Associated with viral infection and immunosupression/ auto-immune conditions
What are apropriate investigations for suspected lymphomas?
- FBC with differentials
- abnormalities if BM involvement
- Blood smear
- Reed-sternberg cells
- Lymph node biopsy
- different for Non-Hodgekin and Hodgekin Lymphomas


